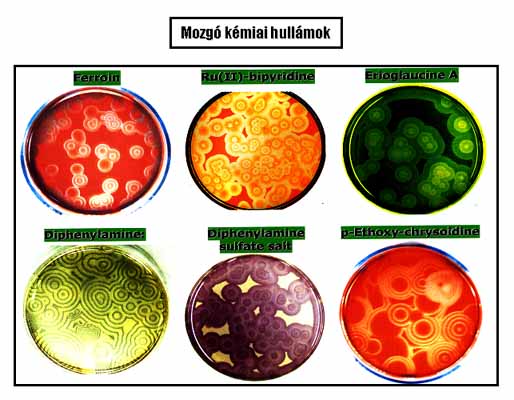

1. ábra: A kémiai oszcilláció kutatásának
időszakai
ORBÁN MIKLÓS
Oszcilláló kémiai reakciók:
Múlt, jelen, jövő
Akadémiai székfoglaló előadás
2004. december 14.
Bevezetés
Az oszcilláló vagy (más néven) periodikus jelenségeket a fizikában, a biológiában és az asztrológiában már régóta ismerik és régóta tanulmányozzák. Gondolhatunk például a mechanikai inga mozgására, az elektromos rezgőkörben fellépő áram és feszültés oszcillációkra, mint fizikai példákra, az élő szervezetekben előforduló biológiai ritmusokra, az állatfajok populációs dinamikájára, mint biológiai példákra, vagy a bolygók periodikus mozgására, a Saturnust körülvevő koncentrikus köralakzatokra, mint kozmológiai példákra.
A kémiai változásokból eredő, azt kísérő periodikus jelenségek rendszeres kutatása azonban csak rövid, alig 4 évtizedes múlttal rendelkezik. A kémia lemaradása a többi tudományággal szemben meglepő, hiszen – ha szórványosan is – kémiai periodicitásra utaló megfigyelésekről jóval korábbi feljegyzések is beszámolnak. Robert Boyle már a XVII. század végén leírta, hogy foszfor oxidációjakor periodikusan felvillanó lumineszcencia észlelhető.1 Fechner 1828-ban potenciál oszcillációt mutatott ki elektrokémiai rendszerben.2 A századforduló körül több kutató periodikus H2 fejlődést tapasztalt fémek savban való oldásakor. 3 Morgan 1916-ban a szénmonoxid ritmikus keletkezését figyelte meg hangyasav bomlási reakciójában.4 Bray 1921-ben a H2O2 jodát-katalizált bomlásakor az oxigén pulzusokban történő fejlődése mellett a jód koncentrációjának periodikus változásait is kimutatta.5 Belousov 1951-ben a citromsav bromátos oxidációjában a reakcióelegy színének oszcillációját tapasztalta.6 Mindezek a korai megfigyelések azonban az 1960-as évek közepéig észrevétlenek maradtak.
Az 1964-es év mérföldkő a homogén közegű oszcilláló kémiai reakciók kutatásában. Az érdeklődés az oszcilláló kémiai reakciók iránt ugrásszerűen megnőtt, amikor Zhabotinsky továbbfejlesztette Belousov kísérleteit és megadta a Belousov reakció vázmechanizmusát,7 Chance felfedezte az első biokémiai oszcillátort (a glikolízis oszcillációs lefolyását),8 továbbá Prigogine által kifejlesztett irreverzibilis termodinamika9 alapján lehetővé vált a periodikus kémiai folyamatok elméleti értelmezése.
1964-től számítjuk azt az időszakot, amelyben az oszcillációs jelenségek kutatása – nemlineáris kémiai dinamika néven - önálló és rohamosan fejlődő diszciplinává vált, köszönhetően elsősorban a kísérleti technikák fejlődésének (CSTR, CFUR,…), számítógépek alkalmazásának (szimulációk), továbbá más tudományágakhoz való kapcsolódás (interdiszciplinaritás) felismerésének.
A kémiai oszcillációs jelenségek kutatásába 1973-ban kapcsolódtam be. Az alapfogalmakat a BZ rendszer tanulmányozásával sajátítottam el. 1978-tól kezdődően foglalkozom új oszcilláló kémiai reakciók előállításával, az új rendszerek dinamikai viselkedésének feltérképezésével, és a periodikus jelenségek kémiai hátterének feltárásával.
Előadásomban bemutatom és rendszerbe foglalom a ma ismert oldatfázisú oszcilláló kémiai reakciókat és megnevezem azokat, amelyeket laboratóriumunk állított elő 1978 és 2004 között. Ezt az időszakot 3 részre osztom: múlt – jelen – jövő időszakokra. A “múlt”-ban elért eredményeinkről az 1998-es székfoglalómban már beszámoltam. Ezekből most csupán annyit ismételek, amennyi szükséges a “jelen” eredményeinek beillesztésére a korábbi ismeretek közé. A “jelen” eredményeiről részletesebben szólok. Eredménynek tekintem azt is, ha a saját előállítású rendszereinket más laboratóriumokban tanulmányozzák, akár tudományos, akár alkalmazási céllal. A “Zárszóban” a nemlineáris kémiai dinamika jövőbeni fejlődési irányait próbálom megjósolni. A kémiai oszcilláció kutatásának kezdeteit és a jelen székfoglalóban összefoglalt munkához kapcsolódó időszakokat az 1. ábrán mutatom be.

1. ábra: A kémiai oszcilláció kutatásának
időszakai
Kémiai oszcillációs jelenségek
Az oszcilláló kémiai reakciók bemutatása
és rendszerezése előtt néhány mondatban összefoglalom
a
kémiai eredetű periodikus jelenségeket.
Kémiai oszcillációról akkor beszélünk, amikor egy kémiai rendszerben
a résztvevő speciesek koncentrációja nem
monoton, hanem periodikusan változik.
Koncentráció oszcilláció jelentkezhet az időskálán,
ekkor
beszélünk oszcilláló kémiai reakcióról. Az oszcillációk
színes
köztitermék képződése esetén vizuálisan
is követhetők, de legtöbbször csak műszerrel regisztrálhatók, az oszcilláló
komponens valamely – a koncentrációjával arányos – jelének (pl.
a fényabszorpciónak, az elektródpotenciálnak, stb.) mérése útján. A fizikai-kémiai
értelemben vett zárt rendszerben az idő
függvényében mért oszcillációs jelek csillapított amplitudóval követik
egymást, majd megszűnnek, amikor a rendszer közelíti, vagy eléri
a termodinamikai egyensúlyt. Az oszcillációk azonban
csillapítatlan amplitúdóval tetszőleges ideig fenntarthatók nyitott
rendszerben, pl. áramlásos kevert tankreaktorban (CSTR), amelyben
a folyamatos reagensbetáplálás biztosítja az egyensúlytól távoli állapotot.
Az oszcillációs jelek legtöbbször egyszerű
szerkezetűek. Lehetnek azonban különböző
alakú összetett, de szabályos
formájúak és néha nagyon szabálytalanok,
aperiodikusok. Ez utóbbi változatot hívjuk kémiai káosznak.
A periodikus egyszerű és összetett, valamint az aperiodikus redoxipotenciál
vs
idő görbék láthatók a 2. ábrán.

2. ábra: Időbeni kémiai oszcillációk: periodikus egyszerű (a, h), periodikus komplex (b-c, f, g) és aperiodikus (a-d) oszcillációk a ClO2- - S2O32- áramlásos rendszerben

3. ábra: Térbeni kémiai oszcilláció:
egyszerű dinamikus mintázatok (mozgó koncentrikus körök és spirálok)

4. ábra: Összetett (időben és térben
periodikus) kísérletileg előállított struktúra
Koncentráció oszcillációk nemcsak időben, hanem a térkoordináták mentén is kialakulhatnak. Konvekció mentes vékony oldatrétegben, gélben vagy membránon, az oszcillációs kinetika és diffúzió következtében, kémiai mintázatok képződhetnek. Ezek 2 változatban, dinamikus vagy stacionárius formában jelenhetnek meg. A dinamikus szerkezetek mozgó kémiai hullámok, amelyek időben növekvő sugarú koncentrikus körök, vagy ezek megzavarásával létrejövő, jobbra vagy balra forgó, egy- vagy több-karú spirálok(3. ábra). Összetett dinamikustérbeni szerkezetek is léteznek. Egy kísérletileg előállított összetett dinamikus szerkezetet mutat a 4. ábra. Szimuláció alapján jósolt még összetettebb struktúrákat láthatunk az 5. ábrán, ezek időben is és térben is periodikusak. Kísérleti keresésük folyamatban van. Stacionárius térbeni struktúrák, azaz állóhullámok is létrejöhetnek. Ilyen szerkezetet képvisel a Turing struktúra,amely szabályosan elhelyezkedő pontok vagy labirintus formájú sávok térben kialakuló mintázata (6. ábra).

5. ábra: Összetett (időben és térben
periodikus) szimuláció alapján jósolt struktúrák

6. ábra: Térbeni kémiai oszcilláció: stacionárius (Turing) struktúrák
A bemutatott jelenségekben az a különlegesség, hogy a kémiai reakciók és fizikai folyamatok kombinációja olyan végállapotot eredményez, amelyben a rendezettség nagyobb mértékű, mint volt a kiindulási állapotban. A homogén rendszer spontán önszerveződése időben vagy térben periodikus szerkezetté látszólag ellentmondásban van a Boltzman-féle általános érvényű rendezetlenségi elvvel. Az ellentmondást az irreverzibilis termodinamika oldja fel.
Aktivátor – inhibitor mechanizmus
Az időben és térben periodikus kémiai jelenségek kialakulása az “aktivátor-inhibitor” mechanizmus alapján értelmezhető. Egy ilyen mechanizmus szerint lejátszódó A —> P bruttó reakcióban aktivátor (X) és inhibitor (Y) tulajdonságú köztitermékek keletkeznek, fáziskéséssel. X keletkezése lassan indul, majd – lévén autokatalitikus species – keletkezése felgyorsul. A később megjelenő Y fogyasztja X-et, leállítja az A + X reakciót, majd termékké alakulva eltűnik a rendszerből. Ezzel zárul az A —> P ciklus. Ha az A-nak van utánpótlása, a ciklus újra és újra indulhat, ami X és Y koncentrációjának az időben történő oszcillációját idézi elő. Az aktivátor – inhibitor mechanizmus működése a 7. ábrán követhető.

7. ábra: Aktivátor – inhibitor mechanizmus
Az “aktivátor – inhibitor” mechanizmus érvényesülése a periodikus jelenségek kialakulásának szükséges, de nem elégséges feltétele. Időbeni oszcillációhoz parametrikus feltételek teljesülése is kell, a rendszer csak bizonyos k érték-intervallumban mutat oszcillációt. Káosz kialakulásához –legalábbis modelreakciókban – minimálisan 3 köztitermék vagy megfordítható reakciólépések feltételezése szükséges. Mozgó kémiai hullámok létrejöttének további feltétele az, hogy az aktivátor és inhibitor molekula diffúzió állandója közel azonos legyen (Dakt» Dinh). Turing struktúracsak akkor jöhet létre, ha az inhibitor diffúzió állandója nagyságrenddel nagyobb az aktivátorénál (Dinh >> Dakt).
A feltételek modelszámításokban, szimulációkban könnyen, a valóságban,kísérletekben lényegesen nehezebben teljesíthetők. Ez az oka annak, hogy a jelenségeket jól tudjuk modelezni, de kevés a laboratóriumi példa. Oszcilláló kémiai reakció viszonylag sok van. Mozgó kémiai hullámokat sokkal kevesebb rendszerben sikerült létrehozni. Oldatfázisban kémiai káoszt csak 3 kísérleti rendszerben észleltek. Turing struktúra eddig csak 1 rendszerrel, a CIMA rendszerrel volt kísérletileg megvalósítható.
Kémiai oszcillátorok csoportosítása: korábbi és újabb példák
A nemlineáris kémiai dinamika összes (eddig ismertetett) jelensége közül a legalapvetőbb viselkedési forma az időbeni koncentráció oszcilláció vagy oszcilláló kémiai reakció. Csak az a rendszer tud káoszt, mozgó vagy stacionárius kémiai hullámokat kialakítani, amelyik – valamilyen körülmények között – időben oszcillációra képes.
Előadásom további részében bemutatom és rendszerbe foglalom a ma ismert oldatfázisú oszcilláló kémiai reakciókat. Azokat a reakciókat sorolom egy csoportba, amelyekben az oszcillációsciklus kémiája hasonló. Ilyen alapon 8 csoport vagy oszcillátor család különböztethető meg, nevezetesen: bromát: (BrO3-), klorit: (ClO2-), oxigén: (O2), hidrogénperoxid: (H2O2), mangán (KMnO4, Mn(IV), MnSO4), H+-ion (pH), bromit: (BrO2-) és Cu(II)-katalizált oszcillátorok.
Bromát oszcillátorok
Felfedezésük Belousov (1951) nevéhez fűződik, aki a BrO3- és citromsav között lejátszódó reakcióban az alkalmazott Ce(IV) katalizátor színének oszcillációját, azaz a Ce(III) és Ce(IV) koncentráció periodikus változását észlelte. Az oszcillátor összetételét Zhabotinsky módosította, citromsav helyett malonsavat alkalmazott, a Ce(IV)-et ferroinnal vagy Mn(II)-vel helyettesítette. A katalizált BrO3- - Malonsav rendszer a híres Belousov-Zhabotinsky (BZ) reakció.
A bromát csoport általános összetétele: Bromát – Szubsztrát – Katalizátor – Sav. A csoportban a BrO3- a közös komponens, amit a szubsztrát redukál. Redukciója Br--ig 5 lépésben történik (8. ábra). A redukciós folyamatban (+) és (-) visszacsatolásos lépések is szerepelnek, tehát az oszcillációs kinetika hordozója a BrO3- redukciója. A BrO3- reagál Br- ionnal is, ezért BrO3- és a Br- között lejátszódó reakció – áramlásos reaktorban és katalizátor jelenlétében – oszcilláló reakció. Az oszcillációt a BrO3- - Br- - Katalizátor rendszerben kísérletileg 1982-ben találtuk meg. Ez a legegyszerűbb összetételű BrO3- oszcillátor, az összes BrO3- oszcillátor magja, ezért a rendszert “minimális bromát oszcillátornak” neveztük el.10

A 9. ábrán a különböző variánsokat mutatom be. A katalizátor és a szubsztrátvariálható. Az alkalmazható szubsztrátok száma kb. 80-90. Ezek között sok szervetlen és még több szerves vegyület található. A szervetlen szubsztrátú BrO3- oszcillátorok (egy kivétellel) csak nyílt rendszerben, a szerves szubsztrátumúak zárt rendszerben is oszcillálnak. A variánsok 70 %-a csak katalizátorral (BZ rendszerek), kb. 30 %-a katalizátor nélkül is (UBO rendszerek) működik. (Az ábrán bekereteztük a saját előállítású rendszereket, amelyek a variánsok kb. felét teszi ki).

Gondolom – sokukban felmerülő kérdés, hogy mire jó ez a sok variáns? Miért keresünk újakat, amikor már van elég belőlük? A válasz a következő: Mindegyik variáns többé-kevésbé különböző, bármelyik lehet valamilyen szempontból érdekes. Az oszcillációs ciklus kémiáját alapvetően a BrO3- ion szabja meg, de a dinamikai viselkedés gazdagsága elsősorban a szubsztráttól függ. Példaként hasonlítsuk össze a BrO3- - Ce(IV) - Br- (“minimális”) és a BrO3- - Ce(IV) – Malonsav (BZ) variánsokat: A BrO3- - Ce(IV) - Br- oszcillátor kémiai mechanizmusa egyszerű, 7 elemi lépésben megadható. Oszcillációra csak egy szűk paraméter tartományban és csak áramlásos reaktorban képes. A malonsavas változat, a BZ reakció, mechanizmusa igen bonyolult, 100 elemi lépés felírása is kevés a pontos kémiai jellemzéshez. Dinamikai viselkedése rendkívül sokszínű: oszcillál zárt rendszerben is, mutatja a káosz jelenséget, álló és mozgó struktúrák létrehozására egyaránt alkalmas, stb. a BZ rendszer sokoldalúsága miatt elnyerte az oszcilláló kémiai rendszerek “állatorvosi lova” címet.
A BZ rendszernek, sokoldalúsága ellenére hibája is van: a reakció végterméke CO2 gáz, ami zavarja a kémiai mintázatok kifejlődését, ezáltal azok időbeni tanulmányozását. Kerestük és az utóbbi években meg is találtuk a mintázatképződés tanulmányozására a BZ-nél alkalmasabb variánsokat. A zárt rendszerben is működő BrO3- - Ciklohexándion - Indikátor és a BrO3- - H2PO2- - Aceton – Mn(II)/Ru(II) összetételű oszcillátorainkban buborékmentes, több órán át is fennmaradó kémiai hullámok állíthatók elő.11 A 10. ábrán láthatók a CHD szubsztrátos BrO3- oszcillátorban a különböző indikátorok illetve katalizátorok jelenlétében kialakuló kémiai hullámok.
10. ábra: A BrO3– – CHD – Indikátor rendszerben
kialakuló (a valóságban vörös, sárga, zöld, kék, narancs és lila színű)
mozgó kémiai hullámok
A BrO3- - CHD – Indikátor rendszer mechanizmusát is meghatároztuk. Tisztáztuk a CHD oxidációs lépéseit, a BrO3- redukciókinetikáját, az aktivációs, az inhibiciós és a regenerálódási folyamatokat, elvégeztük a periodikus viselkedés számítógépes szimulációját.12 A rendszerünket jelenleg az amerikai Floridai Egyetemen (University of Florida)13) és a kanadai Windsor Egyetemen (University of Windsor)14 tanulmányozzák és több, más rendszerekben még nem tapasztalt hullámdinamikai jelenséget (anomális diszperzió, hullámtorlódás, hullám-újjászületés…stb.) mutattak ki. Az angliai Cambridge-ben (University of Cambridge)15 NMR technikával vizsgálják a rendszerben észlelt mintázatokat.
Klorit oszcillátorok
Klorit oszcillátorok családja 27 variánsból áll. Általános összetételük: Klorit - Szervetlen redukálószer. Összefoglalásuk a 11. ábrán látható. A csoport első képviselőjét 1981-ben, az akkori munkatársam, Patrick De Kepper találta meg két olyan autokatalitikus reakció összekapcsolásával, amelyeknek közös az aktivátora (I2). Az én feladatom volt a bonyolult reakcióban rejlő oszcillációs mag megkeresése.

11. ábra: Klorit oszcillátorok
Először a 4 komponensű rendszert 3, majd 2 komponensűre sikerült redukálni, így jutottunk el a ClO2- - I- összetételű “minimális” verzióhoz. A komponensek csökkentése sok új variáns előállítását eredményezte. A ClO2--I- reakció, malonsav hozzáadásakor zárt rendszerben is oszcillál. Jódotnem tartalmazó klorit oszcillátorok 5 változatát is előállítottuk.
A csoport legjelentősebb tagjai a ClO2- - I-, a ClO2- - I- - Malonsav (CIMA) és a ClO2- - S2O32- reakciók. A ClO2- – I- oszcillátor arról nevezetes, hogy az összes ma ismert oldatfázisú oszcillátor közül ennek a rendszernek legkidolgozottabb a mechanizmusa. A ClO2- - I- reakciósban rejlő oszcillációs kinetika forrása a I2 autokatalitikus keletkezése és a I- ion inhibiciója. A CIMA rövidítéssel ismertté vált rendszert ma sok laboratóriumban, elsősorban Bordeauxban (Franciaország), Austinban (USA), Walthamban (USA) és Santiago de Compostella-ban (Spanyolország) – használják a Turing által elméletileg már 1952-ben megjósolt, de kísérletileg csak 1990-ben előállított Turing szerkezetek tanulmányozására. A ClO2- - S2O32- oszcillátor két okból is említést érdemel: (a) ez a reakció a “bolond óra”, óra, mert óra reakció, de bolond, mert minden alkalommal más időben indul el, néha egy perc, néha egy óra múlva, (b) ebben találtuk meg az oldatfázisban kísérletileg előállított kémiai káosz második példáját.
Oxigén oszcillátorok
Az O2 oszcillátorokban az oxidálószer a vízben oldott oxigén. Összetételüket a 12. ábrán mutatom be. Ebből a csoportból laboratóriumunk nem állított elő képviselőt.

Szoros kötődésünk van azonban a 12. ábra 1. pontjában említett O2 – S2– – SO32– – Metilénkék összetételű u.n. “metilénkék-oszcillátorhoz”, amely kapcsán éles tudományos vitába keveredtünk egy jónevű német kutatócsoporttal (vezetője Arnold F. Münster). A német laboratórium – több publikációban és konferencia előadásban – bejelentette, hogy a metilénkék- oszcillátorral, speciális körülmények között, látványos színű és változatos mintázatú Turing struktúrákat állítottak elő.16 A bejelentés azért váltott ki nagy visszhangot, mert ez a kísérlet eredményezte (volna) a laboratóriumban előállított Turing struktúra második példáját. Mint már említettem, eddig ez csak egy rendszerben, a CIMA rendszerben sikerült. A metilénkék-oszcillátorral előállított Turing struktúra vizsgálatára több kutatócsoport, a miénk is, azonnal ráállt. Az eredeti közleményben leírt receptet követve a szerkezeteket mi is észleltük. De egyben azt is kimutattuk, hogy a pontokból vagy csíkokból, sávokból álló képződmények csak formailag hasonlítanak a Turing struktúrához, de eredetüket tekintve, ehhez nincs semmi közük. A problémára részletesebben kitérek:
A Münster-féle kísérletben a metilénkék-oszcillátor komponenseit egy poliakrilamid (PAA) gélrétegbe ágyazták, a gélre a metilénkék vizes oldatát rétegezték. Az O2 a levegőből ezen az oldaton át került a rendszerbe. A “Turing szerkezet” – a gélrétegben – 15-20 perc után jelent meg és fejlődött ki először kék pontok, majd csíkok formájában és maradt fenn 1-2 óráig (13. ábra felső része).

13. ábra: A “metilénkék – oszcillátorral” előállított “Turing-szerű” struktúrák
Kísérleteinkben észrevettük, hogy ugyanolyan kinézésű, de fehérszínű pontok illetve csíkok jelennek meg a világosszürke gélben, ha a metilénkéket, az oszcillációs ciklus hordozóját, teljesen kihagyjuk a rendszerből (13. ábra alsó része). Az O2 és S2- között lejátszódó reakció nem oszcilláló rendszer, tehát a szerkezet nem lehet az aktivátor-inhibitor mechanizmus alapján kialakuló reakció-diffúzió-s szerkezet, nem lehet Turing struktúra. Bebizonyítottuk, hogy az észlelt mintázat a szulfidot tartalmazó gélréteg készítésekor alakul ki. A gélesedés alatt felszabaduló jelentős exoterm hő miatt a még folyékony rétegben konvekciós áramok keletkeznek. Az áramok mentén a polimerzációt inhibiáló O2-nel való érintkezés következtében konvekciós mintázat képződik, amely a gél megszilárdulásakor rögzítődik. Ez a szerkezet láthatatlan. Láthatóvá akkor válik, amikor vízzel (vagy metilénkék oldattal) értintkezik. A S2--tartalmú gél, ellentétben a tiszta PAA-dal, jelentős mértékben és egyenetlenül duzzad, ami a gélben levő szerkezetet előhívja.
Érveinket az “új Turing struktúra” létezése ellen a Chemical Physics Letters17 és a Journal of Physical Chemistry18 folyóiratokban közöltük. A kérdés véglegesen az 1999-es Gordon Konferencián a témáról tartott előadásunk után, az azt követő vitában dőlt el. Az eredmény: a Turing szerkezetnek kikiáltott mintázat visszaminősült egy közönséges hidrodinamikai jelenségen alapuló Benárd-féle szerkezetté, olyan fizikai szerkezetté, amely hőmérséklet-gradiens hatására tiszta folyadékok vékony rétegében is könnyen előállítható.
Hidrogénperoxid oszcillátorok
A H2O2 oszcillátorok működése a H2O2 bomlási reakcióján alapul, amely speciális katalizátor jelenlétében periodikus lefolyású. Öt oszcillátortismerünk ebből a csoportból. A bruttó folyamatot és a részreakciókat, valamint az oszcillátorok összetételét a 14. ábrán tüntettem fel. Az 1. sorszámú rendszer, a H2O2-nak jód-katalizálta bomlása, a híres Bray reakció 1921-ből. A 2. sorszámú az 1. rendszer változata, a Briggs-Rauscher reakció.

14. ábra: H2O2 oszcillátorok
A 14. ábrán 3. sorszám alatt említett saját előállítású H2O2 - SCN- - Cu(II) oszcillátor zárt rendszerben is hosszú ideig működő szín és potenciál oszcillációkra képes. Egyszerű kivitelezhetősége és jó reprodukálhatósága miatt sok laboratóriumban használják. Spanyol (University of Cordoba) 19 és olasz (Universitŕ di Bologna)20 kutatók analitikai célraalkalmazzák. Mikromennyiségű szerves anyagok (pl. vanillin, paracetamol, aszkorbinsav,…) meghatározására kinetikus módszert dolgoztak ki, ami azon alapszik, hogy a Cu(II) katalizátorral kölcsönhatásba lépő anyagok a koncentrációjuk arányában változtatják meg az oszcilláció paramétereit. Német kollégák (Würtzburg21 és Drezda22) oszcilláló lumineszcenciajelenségét tanulmányozták a rendszerrel, amely luminol hozzáadásakor periodikus fényimpulzusokat bocsájt ki, vagy vékony oldatrétegben világító dinamikus szerkezetek kialakítására képes.
Mangán oszcillátorok
Mangán oszillátorok működése az oldható Mn(IV) köztitermék autokatalitikus keletkezésén alapszik, amely akár a Mn(VII) redukciójával, akár a Mn(II) oxidációjával megvalósítható. A (-) visszacsatolást az oldott Mn(IV)-nek MnO2 csapadék formájában történő szabályozott sebességű kiválása biztosítja. A szabályozás a Mn(IV) specieszt stabilizáló XO4n– összetételű reagenssel történik. A 15. ábrán láthatók az alkalmazott oxidáló- és redukálószerek, illetve stabilizátorok, ezek kombinációjából származnak a variánsok. Kb. 30 variáns ismert, amelyek legalább 90%-át laboratóriumunk állította elő. Közülük a legfontosabb és legrészletesebben tanulmányozott a MnO4--Mn2+-Stabilizátor összetételű “minimális” rendszer és a Mn2+- IO4- reakció. Példaként bemutatom a MnO4- - IO4- oszcillátor igen egyszerű mechanizmusát és a mechanizmussal végzett szimulációk eredményét, amely teljesen egyezik a kísérletileg tapasztalt viselkedéssel (16. ábra).

15. ábra: Mangán oszcillátorok kiindulási komponensei: oxidálószerek,
redukálószerek és stabilizátorok

16. ábra: A MnO4- - IO4- oszcillátor mechanizmusa és a mechanizmus alapján szimulált időbeni oszcillációk
A Mn-oszcillátorok kutatása jelenleg is témánk. A közelmúltban egy olyan új, 3 tagú alcsoportot állítottunk elő, amely oszcillációs ciklusában és dinamikájában is különbözik a korábbiaktól.23 Az új alcsoport kémiai összetétele: KMnO4 vagy oldható MnO2 vagy Mn2(SO4)3 – H2PO2-. Az oszcillációk csak galvanikus elrendezésű cellában, Pt elektródon jelentkeznek, az oldatban nem kimutathatók. Az új rendszerek nemcsak nyitott, hanem zárt rendszerben is oszcillálnak (a 17. ábrán láthatók a Mn(VII) / Mn(IV) / Mn(III) - H2PO4- - Pt rendszerekben zárt, félig nyitott és nyitott kísérleti körülmények között regisztrált, 400 – 600 mV amplitúdójú potenciál oszcillációk). Az új csoport nyitott áramkörű elektrokémiai oszcilláló reakciók közé sorolható, ahol a Mn(III)-nak a Pt felületén történő redukciója játszódik le oszcillációs kinetika szerint.

17. ábra: A Mn(VII/IV/III) – H2PO2––
Pt
rendszerben mért potenciáloszcillációk zárt, félig nyitott és nyitott rendszerben
H+ ion oszcillátorok (pH oszcillátorok)
A pH oszcillátorokban a sorozatos vagy párhuzamos kémiai reakciók által bekövetkező pH változások idézik elő azokat a (+) és (-) visszacsatolásokat, amelyek az oszcillációs ciklust kialakítják. A pH oszcillációja tehát nem következménye, hanem hajtóereje az oszcillációs kinetikának. A pH oszcillátorokban a pH akár 3–4 egységet is változhat egy oszcillációs ciklusban. A 18. ábrán példaként bemutatom a IO3- - SO32- - Fe(CN)64-rendszerben regisztrált pH oszcillációkat.

Egy pH oszcillátor 2 lényeges részreakciót tartalmaz: az egyik H+ termelő autokatalitikus reakció, a másik H+ fogyasztó folyamat. Oszcilláció a pH-ban akkor áll elő, ha a részreakciók időben elkülönülve játszódnak le. A két részreakció megvalósítható egy szubsztráttal, annak részleges, majd teljes oxidációjával, vagy két különböző szubsztráttal. Az egy-szubsztrátos változatok száma 6, ezekben a redukálószer kén és nitrogén vegyület, az oxidálószer H2O2, IO3- vagy IO4- (19. ábra). A két-szubsztrátosok száma 11. Itt a H+-termelő folyamat a SO32- oxidációja kénsavvá, a H+-fogyasztó lépés a másik szubsztráttal történő reakció (20. ábra). Mindkét típusú pH oszcillátor első képviselőit laboratóriumunk állította elő.

19. ábra: Egy-szubsztrátos pH oszcillátorok

20. ábra: Két-szubsztrátos pH oszcillátorok
Jelenleg sok kutató foglalkozik pH oszcillátorok előállításával és alkalmazási lehetőségeivel. Néhány példát említek: (1) 2000-ben olyan szabadalmat nyújtottak be (Cambridge, MA, USA),24 amely pH oszcillátorok használatát javasolja periodikus gyógyszeradagolás iniciátoraként. Az elképzelés szerint a gyógyszerből a hatóanyagot a pH oszcillátor a maximális vagy minimális pH-n szabadítaná fel, ami egy membránon átjutva a bőrön keresztül szívódna fel. (2) A IO3--SO32--Fe(CN)64- pH oszcillátorunkkal Austinban (University of Texas, USA)25 többféle stacionárius és időfüggő periodikus és aperiodikus térbeni struktúrákat állítottak elő membránon, nyitott reaktorban. (3) A BrO3--SO32--Fe(CN)64-pH oszcillátor különösen népszerű a mért nagy pH változások és széles oszcillációs tartománya miatt. Jelenleg 2 laboratóriumban használják:
(a) Sheffield Egyetemen (University of Sheffield, UK)26 u.n. “molekuláris motor” szerkesztésén dolgoznak, ami az oszcilláló reakció kémiai energiáját mechanikai munkává alakítja. Olyan hidrogélt helyeztek a BrO3--SO32--Fe(CN)64- pH oszcillátorba, amelynek térfogata több 100 %-ot változik, amikor a pH a minimális értékről a maximálisra vált. A gél periodikus tágulása és összehúzódása egy munkavégzésre alkalmas mechanikus szerkezetet működtet. (b) Laboratóriumunkban (ELTE) indukált oszcillációk előállításra használjuk a BrO3--SO32--Fe(CN)64- pH oszcillátort (l. később).
Cu(II)-katalizált oszcillátorok
A Cu(II)-katalizált oszcillátorok a kén-vegyületek oxidációjával kapcsolatosak. Az oszcillációs ciklusban a szubsztrát a Cu(II)-t redukálja és a keletkező Cu(I)-et átmenetileg stabilizálja, így az oxidálószer csak késleltetve képes a Cu(II) regenerálására. A 4 ismert oszcilláló rendszert és az oszcillációs ciklust a 21. ábrán mutatom be. A kén-vegyületek oxidációja Cu(II) katalizátor nélkül lassú, monoton reakció, Cu(II) ionok jelenlétében a reakciók felgyorsulnak. [Cu(II)] = 5 x 10-6 – 8 x 10-5 M alkalmazásakor CSTR-ben egyszerű és komplex oszcilláció valamint, többféle bistabilitást alakul ki. Több vagy kevesebb réz(II) nem vált ki oszcillációt.

21. ábra: Réz(II)ion-katalizált oszcillátorok
Érdekes története van a szűk koncentráció tartományban fellépő Cu(II)-katalizált oszcillációk megtalálásának. A H2O2 és S2O32- közötti reakciót más céllal vizsgáltam, de oszcillációkat észleltem. Az oszcilláció kizárólag akkor jelentkezett, ha a vegyületeket a Múzeum körúti pincében levő laboratóriumban reagáltattam. Hiába próbálkoztam a kultúráltabb emeleti laborban, más épületben, sőt más városban. A csak pincében észlelhető oszcilláció oka az volt, hogy ott egy rézből készült desztilláló készülék szolgáltatta a tiszta vizet, amely – szennyezésként – éppen az optimális 10-5 M Cu(II)-t tartalmazta.
Mostanában nem kerestünk új Cu(II)-katalizált oszcillátorokat, de azért hallunk róluk. A 2004-es ESF konferencián beszámoltak arról, hogy a H2O2-S2O32-–Cu(II) rendszer gazdag dinamikáját modellezik a Prágai Egyetemen (Igor Schreiber et al), a S2O32- - S2O82-–Cu(II) rendszerünket pedig a Palermoi Egyetemen (Maria Turco Liveri et al) gyökös polimerizáció iniciatoraként próbálják alkalmazni azzal a céllal, hogy műanyagot oszcillációs folyamatban állítsanak elő (model számítások bizonyították, hogy az oszcilláló folyamat nagyobb hatásfokú, mint a stacionárius, ami - a biológusok szerint – egyik oka lehet annak, hogy a biológiai evolúció sok oszcillációs ciklust alakított ki az élő szervezetekben).
BrO2- oszillátorok
A BrO2- oszillátorokkal székfoglalómban nem foglalkozom, csak a teljesség kedvéért sorolom fel a 3 ismert variánst a 22. ábrán. Előállításuk és kutatásuk jelentős korlátja az, hogy a NaBrO2 reagens 10 éve nem kapható a kereskedelemben, laboratóriumi előállítása pedig igen körülményes. Érdekességként megjegyzem, hogy a BrO2- oszcillátorok kémiai mechanizmusukban alapvetően eltérnek mind a formailag hasonló ClO2-, mind a BrO3- alapú oszcillátoroktól.

A “jelen” kihívásai
Az oszcilláló kémiai reakciókkal kapcsolatos alapkutatásokban – jelenleg – 3 probléma, illetve feladat megoldása jelent kihívást: (1) Zárt rendszerű pH oszcillátor kifejlesztése; (2) Oszcilláció és rokon jelenségek előidézése emulziókban (kapcsolódás a nano-rendszerekhez) és nem-vizes közegekben; (3) Periodikus koncentráció oszcillációk létrehozása nem-vegyértékváltó ionokkal. Laboratóriumunkban a (3) feladat megoldásán dolgozunk kb. 1 éve és jelentős részsikert értünk el: spontán lejátszódó kémiai folyamatban periodikus Ca2+, Al3+ és F- koncentráció oszcillációkat indukáltunk és regisztráltunk.
Mint az előadásomban bemutatott példák is demonstrálták, a ma ismert összes oldatfázisú oszcilláló kémiai rendszer működése redoxi kémián alapul. Koncentráció oszcillációt laboratóriumban csak azokkal az elemekkel tudtunk létrehozni, amelyek több stabil oxidációs állapotban léteznek. Számos biológiai példa bizonyítja, hogy pl. a Ca2+, K+, Na+, stb., amelyeknek oldatfázisban csak 1 stabil oxidációs számuk van, élő sejtekben résztvesznek periodikus folyamatokban. Igény és kihívás tehát olyan kémiai rendszerek létrehozása, amelyekkel a biológiai oszcillációk modellezhetők.

Módszerünk elvét a 23. ábrán mutatom be. Minthogy (+) és (-) visszacsatolásokon alapuló oszcillációs ciklus a nem-vegyértékváltó ionokkal nem valósítható meg, kerülő utat választottunk. Egy már ismert – redoxi kémián alapuló – oszcilláló rendszert kapcsoltunk össze olyan egyensúlyi reakcióval, amelyben a célelem (ion) részt vesz. Ha a kémiai oszcillátor valamelyik oszcilláló komponense erősen befolyásolja az egyensúlyi reakció irányát és mértékét, ugyanakkor az egyensúly nem (nagyon) zavarja az oszcillátor működését, akkor az egyensúlyban résztvevő komponensek koncentrációja a primer oszcillátor frekvenciájával oszcillál.
Ca2+, Al3+ és F- koncentráció oszcillációk előállításához a kiválasztott induktor a BrO3--SO32--Fe(CN)64- pH oszcillátor volt, amelyben a pH 2.7 – 6.3 között oszcillál 20-25 perces periódus idővel.
Ca2+-ion oszcillációk előállításához a pH érzékeny Ca2+ + EDTA - CaEDTA komplexképződési egyensúlyt kapcsoltuk a pH oszcillátorhoz. pH ~ 3-nál komplex nem képződik, azaz az összes kalcium ionos formában van jelen. pH ~ 6–nál teljes a komplexképződés, szabad Ca2+ ion nincs az oldatban. A BrO3--SO32--Fe(CN)64--CaEDTA rendszerben tehát a pH oszcillátor frekvenciájával megegyező Ca2+ ion pulzusok keletkeznek, amelyek Ca2+-ISE-dal regisztrálhatók (24. ábra), vagy Ca2+-indikátorral (Arzenazo-III komplexképzővel) vizuálisan is követhetők.

24. ábra: Ca2+-ionkoncentráció oszcillációk a BrO3--SO32--Fe(CN)64--CaEDTA
áramlásos
rendszerben
Al3+ion oszcillációhoz kiválasztott egyensúly az Al3+ + 3OH- - Al(OH)3 csapadékképződési reakció volt. Az Al(III) a minimális pH-nál szabad Al3+ ion formában, a maximális pH-nál kötött Al(OH)3 alakban van jelen. A 25. ábrán látható, hogy az oldat alacsony pH értéknél kristálytiszta, magas pH-nál azonban zavaros, tehát a pH periodikus változása Al3+ ion pulzusokat vált ki.

25. ábra: Al3+-ionkoncentráció oszcillációk a BrO3--SO32--Fe(CN)64--Al(NO3)3
áramlásos rendszerben
F- ion oszcilláció előállításához (amit nem részletezek), a pH oszcillátort két konszekutív egyensúlyhoz, egy csapadékos és egy komplexképződéses reakcióhoz kapcsoltuk. A F--ion pulzusokat F- - ISE-vel regisztráltuk.
Módszerünk mind a kémia mind pedig a biológia számára érdekes lehet. A kémia számára azért, mert más oszcillátorok, más egyensúlyokkal kapcsolva további új oszcillátorok, pl. Na+, K+, Mg2+ vagy Cl- oszcillációk előállítását teszi lehetővé. A biológia számára azért, mert az élő szervezetekben előforduló Na+, K+, Mg2+ vagy Cl- stb. oszcillációk egyik lehetséges mechanizmusát szolgáltatja. A módszert leíró és a Ca2+, Al3+, F- oszcillációkat bemutató és biológiai vonatkozásokat tartalmazó kéziratunkat a Nature – 2004. november 22-én – közlésre elfogadta.27
Jövőkép
A nemlineáris kémiai dinamika kutatása gyorsan, publikációkban kifejezve majdnem exponenciálisan nőtt az elmúlt 3 évtized alatt. Eredményei elsősorban az alapkutatások ismerettárát gazdagítják, a gyakorlati alkalmazások száma még szerény. Egyelőre nem lehet pontosan látni, hogy milyen irányba fejlődik. Az biztosan mondható, hogy olyan kísérleti és elméleti módszerek kifejlesztése, amelyekkel tervezni és szabályozni lehet a kémiai dinamikai jelenségeket, a kutatások egyik fő célja marad. Valószínűnek látszik az is, hogy olyan komplex kutatások kezdődnek, amelyekben a nemlineáris kémiai reakciókat fizikai folyamatokkal, pl. a hidrodinamikával, elektromos, mágneses és gravitációs erőtérrel kombinálva tanulmányozzák. A biológiával való kapcsolódás erősödése is prognosztizálható, hiszen sok a hasonlóság a kémiai és biológiai periodikus jelenségek között. Például, formailag teljesen azonos a BrO3– – H2PO2– – Aceton – Ru(II)/Fe(II) rendszerben kialakuló spirál alakú kémiai hullám és a nyálkagomba koloniában, táplálék hiánykor fellépő rendeződés vagy a béka petesejt felületén időszakosan megjelenő spirál szerkezet (26. ábra). A hasonló jelenségeknek nem feltétlenül hasonló az oka és magyarázata, az azonban megkérdőjelezhetetlen, hogy az élő szervezetekben előforduló biológiai oszcillációk eredete – az előbbi 2 biológiai szerveződés is – kémiai alapokon nyugszik.

26. ábra: Spirálhullámok kémiai és biológiai rendszerekben
A nemlineáris kémiai dinamika mint kutatási terület jövője és további fejlődése szempontjából szerencsés volna, ha valami áttörő eredmény születne az alkalmazások irányában. Erre elsősorban az anyagtudományok (polimer kémia) területén van esély. Számomra azonban az sem tragédia, ha a nemlineáris kémiai dinamika egyenlőre marad ami volt, egy izgalmas alapkutatási terület, ami alkalmat kínál az előadásomban tárgyalt érdekes és szokatlan jelenségek kísérleti és elméleti tanulmányozására.
Köszönetnyilvánítás
Befejezve előadásom szakmai részét, most – az Akadémiai Székfoglalók hagyományainak megfelelően – a köszönetnyilvánítás következik.
Elsőként említem intézeti főnökeimet, Schulek Elemér, Szabó Zoltán akadémikusokat, akitől a kutatói pályám kezdetén kaptam biztatást és támogatást. Kőrös Endre professzornak az oszcilláló kémiai reakciók témakörének megismerését és a kb. 12 éves eredményes közös munkát köszönhetem.
Az utóbbi 10 évben a tudományos kutatómunkámban a legtöbb segítséget Csörgeiné Dr. Kurin Krisztina egyetemi docenstől kaptam. Krisztina elsősorban a kísérletek tervezésében és kivitelezésében, továbbá az eredmények prezentálásában kiváló. Dr. Szalai István munkatársamat Kőrös Endre professzortól örököltem. István a modellszámítások, szimulációk területén nyújtott segítséget. Mindkettőjüknek köszönöm a közös munkát.
Legfontosabb külföldi kapcsolatom az amerikai Brandeis University-n működő kutatócsoport vezetőjéhez Irving R. Epstein professzorhoz és híres munkatársához Anatol M. Zhabotinsky professzorhoz fűződik. Az amerikai csoporttal, MTA-NSF támogatással, 25 éve dolgozom együtt.
Kiemelten köszönöm munkahelyem az ELTE Szervetlen és Analitikai Kémiai Tanszéken dolgozó kollégáim támogatását, a stimuláló és barátságos környezetet.
Köszönöm az oszcillációs témában tevékenykedő hazai tudományos kollektíváknak, a BMGTE, DE, SZE kutatóinak érdeklődését és kritikáját.
Az anyagi segítségért köszönetemet fejezem ki a Magyar Tudományos Akadémiának és az Oktatási Minisztériumnak, a National Science Foundation-nak és az European Science Foundation-nak (OTKA, FKFP, MTA-NSF, MTA-ESF).
Köszönöm a Kémiai Osztálynak, hogy rendes tagjává léptetett elő.
Köszönöm feleségemnek és családomnak türelmet, megértését és támogatását.
Köszönöm az előadásomon megjelentek megtisztelő
figyelmét.
References